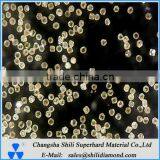
Yellow Industrial Synthetic Diamond Glass Polishing Diamond Powder Price
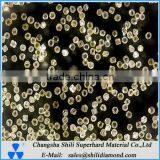
Synthetic Abrasive Powders Diamond Polishing for Glass

Home > Products
Changsha Shili Superhard Material Co., Ltd.
AIBot OnlineThis conversation is AI-generated. Contact manufacturer before transaction to confirm info.
-
Ada Tan
Hi there! Welcome to my shop. Let me know if you have any questions.
Your message has exceeded the limit.
All Products
Chat Now
-
Synthetic Diamond-MBD4 for Diamond Grinding Wheel
- FOB Price: Negotiable
- Min. Order: 1 Grams
-
Synthetic Diamond-MBD4
- FOB Price: Negotiable
- Min. Order: 1 Grams
-
Synthetic Diamond Abrasive Powder for Grinding
- FOB Price: Negotiable
- Min. Order: 5 Grams
-
Best Quality Synthetic Diamond Powder
- FOB Price: Negotiable
- Min. Order: 200 Grams
-
Industrial Synthetic Cu Coating Diamond Powder
- FOB Price: US$ 0.043 / Carat
- Min. Order: 1000 Carats
-
Excellent Metal Bond Diamond Grits for Diamond Wheel
- FOB Price: US$ 0.029 / Carat
- Min. Order: 1000 Carats
-
All Size CBN Cubic Boron Nitride for Cbn Superfinishing Whetstone
- FOB Price: US$ 0.12 / Carat
- Min. Order: 1000 Carats
-
Industrial Abrasives Dark Brown CBN Cubic Boron Nitride
- FOB Price: US$ 0.12 / Carat
- Min. Order: 1000 Carats
-
Hot Sale Dark Brown CBN Cubic Boron Nitride Used for Metal Bond Cbn Tools
- FOB Price: US$ 0.12 / Carat
- Min. Order: 1000 Carats
-
Perfect Abrasives CBN Cubic Boron Nitride Price per Carat
- FOB Price: US$ 0.12 / Carat
- Min. Order: 1000 Carats
-
Best Industrial Abrasives Amber Cubic Boron Nitride CBN Powder Price per Carat
- FOB Price: US$ 0.12 / Carat
- Min. Order: 1000 Carats
-
Superhard Material Cubic Boron Nitride CBN Mono Crystal Powder Price per 1 Carat
- FOB Price: US$ 0.12 / Carat
- Min. Order: 1000 Carats
-
Reliable China Supplier Amber Transparent Cubic Boron Nitride CBN Powder
- FOB Price: US$ 0.12 / Carat
- Min. Order: 1000 Carats
-
High Quality Low Price Diamond Mircon,micro Powder
- FOB Price: US$ 0.023 / Carat
- Min. Order: 1000 Carats
-
Superhard Abrasives Materials Diamond Mirco Powder Polishing Graphite
- FOB Price: US$ 0.023 / Carat
- Min. Order: 1000 Carats
-
Cubic Boron Nitride CBN Powder, Cbn Grits, Cbn Dust
- FOB Price: US$ 0.12 / Carat
- Min. Order: 1000 Carats
-
Yellow Industrial Synthetic Diamond Glass Polishing Diamond Powder Price
- FOB Price: Negotiable
- Min. Order: 1000 Carats
-
Synthetic Abrasive Powders Diamond Polishing for Glass
- FOB Price: Negotiable
- Min. Order: 1000 Carats
-
Small Size Single Crystal Industrial Diamond Powder for Electroplating Tools
- FOB Price: US$ 0.029 / Carat
- Min. Order: 1000 Carats
-
High Purity MBD Diamond Powder Materials for Electroplating Tools
- FOB Price: US$ 0.029 / Carat
- Min. Order: 1000 Carats
-
Made in China High Quality Hpht Yellow Artifical Industrial Abrasive Powder
- FOB Price: US$ 0.029 / Carat
- Min. Order: 1000 Carats
-
Diamond Polish Gems Industrial Glitter MBD Diamond Powder
- FOB Price: Negotiable
- Min. Order: 1000 Carats
-
Made in China High Quality Hpht Yellow Artifical Industrial Diamond Powder
- FOB Price: US$ 0.029 / Carat
- Min. Order: 1000 Carats
-
High Intensity Gold Industrial Diamond Synthetic Dust Powder
- FOB Price: US$ 0.029 / Carat
- Min. Order: 1000 Carats
-
Grinding Tools Used High Grade Gold Industrial Diamond Grit
- FOB Price: US$ 0.029 / Carat
- Min. Order: 1000 Carats
-
On Sale Industrial Metal Bond Diamond Powder for Grinding Wheel
- FOB Price: Negotiable
- Min. Order: 200 Grams
-
Finely Processed Size Abrasives Synthetic Diamond Powder
- FOB Price: Negotiable
- Min. Order: 200 Grams
-
Changsha Supplier Yellow Polishing Industrial Diamond Powder
- FOB Price: Negotiable
- Min. Order: 1000 Carats
-
China Manufacturer Big Size Diamond for Saw Baldes
- FOB Price: US$ 0.041 / Carat
- Min. Order: 1000 Carats
-
Synthetic Industrial Diamond Crystalline Price per Carat
- FOB Price: US$ 0.041 / Carat
- Min. Order: 1000 Carats
New Products
-
Drying Media Corn Cob Grit Polishing Media
-
Alloy Steel Shot
-
Cast Steel Shot/Alloy Steel Shot - Durable and Wear-resistant, Ideal for Long-lasting Shot Blasting Rust Removal.
-
Green Silicon Carbide Powder for Polishing Artificial Quartz Stone Countertops With Magnesite Grinding Blocks
-
Supply 50-500nm Nano Diamond Powder for Precision Polishing
-
Supply 70/80 Diamond Grit Powder for Grinding Wheel Making
-
High Quality W3.5 Diamond Micron Powder for Sapphire Polishing
-
Supply 0.25/0.5/1/2/3 Micron Polycrystalline Diamond Powder
-
High Sharpness 50/60-325/400 Resin Bond Diamond Grit
-
Synthetic Diamond Micron Powder for Ceramic Polishing
-
Good Quality 50/60-400/500 Rvd Diamond Grinding Powder
-
High Quality Synthetic RVD Diamond Grits for Grinding Wheel Making
-
3 Micron Polycrystalline Diamond Powder for Optical Crystals Polishing
-
High Quality Polycrystalline Diamond Powder for Polishing
-
High Quality Synthetic Industrial Diamond Dust Powder for Diamond, Stone Lapping, Rubbing Polishing
-
Flexible Polishing 100mm Wool Felt Wheel Fine Polishing and Mirror Polishing
-
Polishing Wax, in Combination With Cloth Wheel Polishing, Achieves a Mirror-like Polishing Effect
-
Polishing Flat White Cloth Wheel Are Used for Jewelry, Metal, Wood, Ceramics, Glass Mirror Surfaces Jewelry Hardware Grinding
-
Polishing Abrasives Diamond Micron Powder Synthetic Diamond for Polishing
-
Titanium Coated Synthetic Diamond / Coating Diamond Powder
-
Polish Wool Flap Disc 4 1/2 Inch Angle Grinder Attachment for Stainless Steel Aluminum Polishing Metal Surface Chrome Finish for Cars, Trucks, SUVs, RVs, Motorcycles
-
Wool Felt Flap Polishing Disc, Wool Polishing Wheel Disc Buffing Pad, Premium Felt Polishing Pads for Metal, Marble Stone, Furniture Car Wax
-
Supply Polycrystalline Diamond Powder With High Sharpness
-
High Strength Polycrystalline Diamond Powder for Silicong Carbide Polishing
Popular Searches
- steel shot
- silicon carbide
- green silicon carbide
- garnet sand blasting
- sandblast glass bead
- blasting glass bead
- shot blast
- stainless steel shot
- abrasive silicon carbide
- sand blasting abrasive
- steel cut wire shot
- shot blast steel ball
- diode anode
- pyrolytic graphite sheet
- sic kiln silicon carbide
- crystal sand

Drying Media Corn Cob Grit Polishing Media
Alloy Steel Shot
Cast Steel Shot/Alloy Steel Shot - Durable and Wear-resistant, Ideal for Long-lasting Shot Blasting Rust Removal.
Green Silicon Carbide Powder for Polishing Artificial Quartz Stone Countertops With Magnesite Grinding Blocks
Supply 50-500nm Nano Diamond Powder for Precision Polishing
Supply 70/80 Diamond Grit Powder for Grinding Wheel Making
High Quality W3.5 Diamond Micron Powder for Sapphire Polishing
Supply 0.25/0.5/1/2/3 Micron Polycrystalline Diamond Powder
High Sharpness 50/60-325/400 Resin Bond Diamond Grit
Synthetic Diamond Micron Powder for Ceramic Polishing
Good Quality 50/60-400/500 Rvd Diamond Grinding Powder
High Quality Synthetic RVD Diamond Grits for Grinding Wheel Making
3 Micron Polycrystalline Diamond Powder for Optical Crystals Polishing
High Quality Synthetic Industrial Diamond Dust Powder for Diamond, Stone Lapping, Rubbing Polishing
Flexible Polishing 100mm Wool Felt Wheel Fine Polishing and Mirror Polishing
Polishing Wax, in Combination With Cloth Wheel Polishing, Achieves a Mirror-like Polishing Effect
Polishing Flat White Cloth Wheel Are Used for Jewelry, Metal, Wood, Ceramics, Glass Mirror Surfaces Jewelry Hardware Grinding
Polishing Abrasives Diamond Micron Powder Synthetic Diamond for Polishing
Titanium Coated Synthetic Diamond / Coating Diamond Powder
Polish Wool Flap Disc 4 1/2 Inch Angle Grinder Attachment for Stainless Steel Aluminum Polishing Metal Surface Chrome Finish for Cars, Trucks, SUVs, RVs, Motorcycles
Wool Felt Flap Polishing Disc, Wool Polishing Wheel Disc Buffing Pad, Premium Felt Polishing Pads for Metal, Marble Stone, Furniture Car Wax